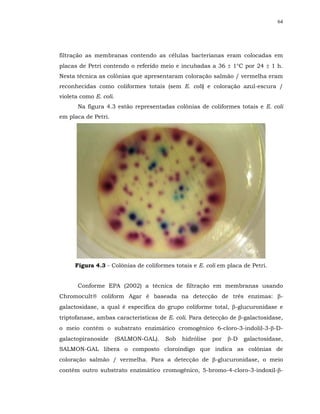
64




filtração as membranas contendo as células bacterianas eram colocadas em
placas de Petri contendo o referido meio e incubadas a 36 ± 1°C por 24 ± 1 h.
Nesta técnica as colônias que apresentaram coloração salmão / vermelha eram
reconhecidas como coliformes totais (sem E. coli) e coloração azul-escura /
violeta como E. coli.
       Na figura 4.3 estão representadas colônias de coliformes totais e E. coli
em placa de Petri.




      Figura 4.3 - Colônias de coliformes totais e E. coli em placa de Petri.


       Conforme EPA (2002) a técnica de filtração em membranas usando
Chromocult coliform Agar é baseada na detecção de três enzimas: β-
galactosidase, a qual é específica do grupo coliforme total, β-glucuronidase e
triptofanase, ambas características de E. coli. Para detecção de β-galactosidase,
o meio contém o substrato enzimático cromogênico 6-cloro-3-indolil-3-β-D-
galactopiranoside       (SALMON-GAL).   Sob   hidrólise   por   β-D   galactosidase,
SALMON-GAL libera o composto cloroindigo que indica as colônias de
coloração salmão / vermelha. Para a detecção de β-glucuronidase, o meio
contém outro substrato enzimático cromogênico, 5-bromo-4-cloro-3-indoxil-β-
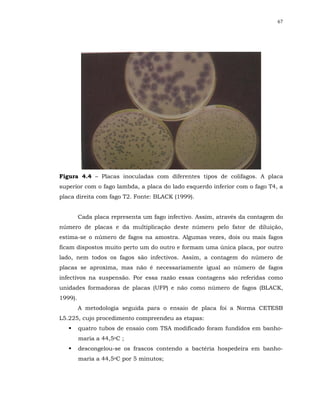
67




Figura 4.4 – Placas inoculadas com diferentes tipos de colifagos. A placa
superior com o fago lambda, a placa do lado esquerdo inferior com o fago T4, a
placa direita com fago T2. Fonte: BLACK (1999).


         Cada placa representa um fago infectivo. Assim, através da contagem do
número de placas e da multiplicação deste número pelo fator de diluição,
estima-se o número de fagos na amostra. Algumas vezes, dois ou mais fagos
ficam dispostos muito perto um do outro e formam uma única placa, por outro
lado, nem todos os fagos são infectivos. Assim, a contagem do número de
placas se aproxima, mas não é necessariamente igual ao número de fagos
infectivos na suspensão. Por essa razão essas contagens são referidas como
unidades formadoras de placas (UFP) e não como número de fagos (BLACK,
1999).
         A metodologia seguida para o ensaio de placa foi a Norma CETESB
L5.225, cujo procedimento compreendeu as etapas:
         quatro tubos de ensaio com TSA modificado foram fundidos em banho-
         maria a 44,5oC ;
         descongelou-se os frascos contendo a bactéria hospedeira em banho-
         maria a 44,5oC por 5 minutos;

Este documento resume uma tese de doutorado sobre a avaliação de métodos de desinfecção de água utilizando cloro, ácido peracético, ozônio e o processo combinado de ozônio/cloro. O documento apresenta os objetivos da pesquisa, revisa a literatura sobre desinfecção de água e doenças hídricas, descreve os materiais e métodos utilizados, e apresenta os resultados e discussões sobre a inativação de microrganismos indicadores e a formação de subprodutos com cada método de






















![9
FIGURA 3.1 – Caricatura de Prey - ‘A sopa de monstros’.
[Fonte: SHOENEN (2002)].
Com o aumento da incidência de doenças de veiculação hídrica
começaram a surgir as primeiras medidas (em grande escala) para o
tratamento da água de consumo, destacando a filtração, que era realizada com
o objetivo de eliminar turbidez e odores, e a desinfecção, cujo objetivo, ainda
baseado em idéias ultrapassadas, era eliminar odores ruins. Assim, a cloração
e a ozonização despontaram como os principais processos de desinfecção.
No início do século XX a cloração foi introduzida de maneira mais
efetiva, objetivando a diminuição da propagação de doenças pela água, o que
indubitavelmente contribuiu para tal fim, destacando como exemplo, a redução
do índice de mortalidade por febre tifóide em todo o mundo na época.
A partir de então, desde que a água de abastecimento passou a ser
clorada, há mais de um século, a cloração exerceu papel dominante e
providenciou segurança microbiológica à água (TRUSSELL, 1999). É um
monopólio tradicional que nenhum outro desinfetante jamais igualou.](https://image.slidesharecdn.com/tesejeanette-121028154321-phpapp02/85/Tese-jeanette-23-320.jpg)




![14
revisados e estabelecidos na Portaria do Ministério da Saúde no 518, de 25 de
março de 2004.
Na Portaria 518/ 2004 não há uma determinação obrigatória para a
pesquisa de patogênicos, porém, no Artigo 11 da mesma, recomenda-se “... a
inclusão de pesquisa de organismos patogênicos, com o objetivo de atingir, como
meta, um padrão de ausência, dentre outros, de enterovírus, cistos de Giardia
spp e oocistos de Cryptosporidium sp” (MS, 2004).
Para SZEWZYK et al. (2000) a meta de completa ausência de todos os
organismos patogênicos na água de abastecimento é difícil de ocorrer,
especialmente mediante os patogênicos emergentes, alguns, inclusive, são
capazes de multiplicarem-se no sistema de distribuição de água.
A CETESB, que avalia a qualidade das águas superficiais do Estado de
São Paulo, monitorou durante 4 anos (janeiro de 1999 a dezembro de 2002) a
concentração dos parasitas Giardia e Cryptosporidium, juntamente com
coliformes termotolerantes, enterococos e C. perfringens, com o objetivo de
conhecer a ocorrência desses parasitas na água, bem como incluir os
resultados num índice de qualidade de água para abastecimento (IAP),
introduzido recentemente. Os dados obtidos foram avaliados tendo como
referência a legislação americana de monitoramento (ICR – Information
Collection Rule), uma vez que, a legislação brasileira não determina o
monitoramento desses protozoários ou quaisquer outros patogênicos em águas
captadas para consumo humano. De acordo com essa regulamentação, seria
necessário monitorar a água tratada em 16 pontos de captação com resultados
positivos na primeira fase do estudo, e em 6 desses pontos da segunda fase,
uma vez que nesses locais foram detectadas concentrações superiores a 10
cistos de Giardia/L ou 10 oocistos de Cryptosporidium/L (HACHICH, 2004).
Nos EUA, trabalha-se com a visão de risco aceitável. A EPA definiu esse
risco como 10-4 anuais, ou seja, uma infecção em cada 10.000 indivíduos por
ano, para doenças adquiridas com o consumo de água tratada. Tal valor
conduz ao conceito de nível aceitável. Na água tratada, o nível aceitável de
oocistos de C. parvum, por exemplo, é de cerca de 6x10-4 /10L [SZEWZYK et al.
(2000), HELLER (2004)].](https://image.slidesharecdn.com/tesejeanette-121028154321-phpapp02/85/Tese-jeanette-28-320.jpg)

![16
percentual dos subprodutos halogenados identificados até o presente
(OXENFORD, 1996; HARMS, 2002).
O residual desinfetante que o cloro providencia ao sistema distribuidor é
outro aspecto relevante a ser levado em consideração. Inclusive, no Brasil, é
exigência de lei.
No Artigo 13 da Portaria 518/2004, fica estabelecido que: “após a
desinfecção, a água deve conter um teor mínimo de cloro residual livre de 0,5
mg/L, sendo obrigatória a manutenção de, no mínimo, 0,2 mg/L em qualquer
ponto da rede de distribuição, recomenda-se que a cloração seja realizada em
pH inferior a 8,0 e tempo de contato mínimo de 30 minutos”.
Há que se considerar também a responsabilidade técnica que recai
sobre o administrador da ETA:
“Admite-se a utilização de outro agente desinfetante ou outra condição
de operação do processo de desinfecção, desde que fique demonstrado pelo
responsável pelo sistema de tratamento uma eficiência de inativação
microbiológica equivalente à obtida com a condição definida neste artigo”
[Parágrafo único, MS (2004)].
Devido a multiplicidade de fatores que envolvem os processos de
desinfecção, não há como avaliar pontualmente o desinfetante, ou o
tratamento mais adequado. As agências de regulação internacionais admitem
que, em muitos casos, o que deve ocorrer é a avaliação de uma estratégia de
desinfecção que envolve condições específicas de cada sistema de
abastecimento. A escolha da estratégia de desinfecção apropriada, se
fundamenta no balanço entre três aspectos principais: água isenta de
patogênicos; controle da formação de subprodutos, e manutenção de residual
desinfetante no sistema distribuidor (USEPA, 1999).
De acordo com HELLER (2004) “é fundamental que se considere a visão
de contexto do problema – do manancial até o ponto de consumo - para se
recomendarem as soluções mais seguras”.
Em relação aos patogênicos, a segurança quanto à ausência ou
presença em níveis seguros, passa por uma visão sistêmica do processo, o que
inclui os conceitos de barreiras múltiplas e de boas práticas no abastecimento](https://image.slidesharecdn.com/tesejeanette-121028154321-phpapp02/85/Tese-jeanette-30-320.jpg)





![22
fluorogênicos baseados em expressões enzimáticas, a detecção simples e
rápida de E. coli e de outras bactérias específicas para fins de monitoramento
de mananciais.
No Brasil, a prática de controle microbiológico de qualidade da água de
consumo se fundamenta no controle da presença de bactérias do grupo
coliformes (DANIEL, 2001). O padrão microbiológico de potabilidade da água
para consumo humano é estabelecido na Portaria MS 518/2004.
As técnicas de detecção de coliformes e E. coli são práticas e
relativamente rápidas. São vários os métodos disponíveis, dentre eles, tubos
múltiplos, contagem em membranas filtrantes e substratos cromogênicos.
Para CERQUEIRA (1999) as técnicas de detecção e identificação de
outros indicadores microbiológicos para funções similares às que são
atribuídas aos coliformes fecais devem ser padronizadas e simplificadas,
podendo-se assim assegurar ausência de microrganismos patogênicos de maior
persistência que essa espécie. Como colifagos, que podem informar sobre a
eficiência do tratamento de água na remoção de enterovírus e outros vírus
como o da hepatite de veiculação hídrica e C. perfringens que, por ser
esporulado, informa sobre poluição fecal mais remota que aquelas indicadas
pela presença de E. coli.
3.3.2 - Colifagos
Os bacteriófagos ou simplesmente fagos são vírus que infectam
bactérias. Foram primeiramente observados em 1915 por Frederic Twort, na
Inglaterra, e em 1917 por Felix D’Herelle, na França. D’Herelle os denominou
bacteriófagos, que significa “comedores de bactérias”. Foram descritos a partir
do trato intestinal humano no início dos anos 1900 e seu uso como modelo
para indicar presença de bactérias entéricas patogênicas começou na década
de 1930 [PELCZAR (1996); BLACK (1999)].
Os fagos que infectam bactérias do grupo coliforme são conhecidos como
colifagos. Como os outros vírus, os fagos podem ter sua informação genética na
forma de RNA ou DNA, fita dupla ou fita simples. Os fagos designados T2, T4 e](https://image.slidesharecdn.com/tesejeanette-121028154321-phpapp02/85/Tese-jeanette-36-320.jpg)
![23
T6 (T de “tipo”) tem o DNA como material genético e os fagos que tem o RNA
como material genético são os colifagos F-RNA e adsorvem-se ao flagelo ou aos
pili [OMS (2002); BLACK (1999)].
Estudos realizados nas décadas de 1970 e 1980, já sugeriam colifagos
como indicadores de qualidade da água e como possíveis modelos de
enterovírus após tratamento de água e esgoto [HILTON & STOTZKY (1973);
KOTT et al. (1978); SCARPINO (1978)]. Colifagos e enterovírus são inativados
em proporção comparável durante os processos de tratamento. Certos colifagos
são tão resistentes quanto alguns enterovírus às condições de estresse
ambiental e à cloração e exibem variação sazonal similar aos enterovirus
[BERG (1974); KOTT et al. (1974); SIMKOVA & CERVENKA (1981)]. Entretanto,
outras pesquisas reportam que a concentração de colifagos aumenta sob
determinadas condições ambientais favoráveis e que colifagos estão presentes
na ausência de vírus detectáveis e vice-versa [VAUGHN & METCALF (1975);
DEETZ et al. (1984)].
STETLER (1984) estudou conjuntamente o monitoramento de bactérias
indicadoras, enterovírus e colifagos em uma ETA. As concentrações dos
colifagos foram determinadas em vários pontos da ETA, incluindo, na água
bruta e após as etapas de floculação-sedimentação, filtração em areia e
cloração. A quantificação de colifagos foi determinada por ensaio de placa,
sendo que para a amostra de água bruta o plaqueamento foi direto e, após as
etapas de tratamento, devido às baixas densidades de colifagos e enterovírus
encontradas, necessitou-se concentrar as amostras, usando técnica de
filtração, eluição e adsorção.
Os dados obtidos pelo autor indicaram que colifagos satisfazem
parcialmente os critérios listados para microrganismos indicadores: colifagos e
enterovírus apresentaram resistência semelhante; a sazonalidade de ambos
também foi semelhante; as concentrações dos fagos na água bruta e após as
etapas de tratamento, excederam as concentrações de enterovírus (com
exceção da cloração, que causou 100% de inativação dos vírus detectáveis); os
processos de tratamento de água removeram / inativaram colifagos e
enterovírus em taxas similares; e ainda, colifagos são facilmente quantificados](https://image.slidesharecdn.com/tesejeanette-121028154321-phpapp02/85/Tese-jeanette-37-320.jpg)







![31
3.4.2 - Inativação de patogênicos e eficácia da desinfecção com cloro,
ácido peracético e ozônio
Durante a cloração a inativação microbiana é influenciada por variações
da sensibilidade dos microrganismos - em geral, a ordem crescente de
dificuldade de desinfecção com cloro compreende bactérias, vírus e
protozoários -, e fatores ambientais tais como pH, tempo de contato, mistura,
turbidez, substâncias interferentes e concentração de cloro disponível. Em
geral, os níveis de inativação de patogênicos mais elevados são obtidos com
alta concentração de cloro residual, longo tempo de contato, temperatura
elevada, mistura eficiente, turbidez e pH baixos, e ausência de substâncias
interferentes [CAIRNS (1995); USEPA, (1999)].
Ainda, a cloração de efluentes contendo amônia forma cloraminas, a
qual, usada como desinfetante primário resulta em drástica redução das taxas
de inativação microbiana. Experimentos de desinfecção de culturas de
laboratório do bacteriófago MS2 com cloraminas produziram inativação menor
que 1 log, após 4 horas de contato, 2 mg/L de cloraminas, 15oC e pH 7
(CAIRNS, 1995).
RICE et al. (1996) realizaram estudo de inativação de esporos aeróbios
selvagens com hipoclorito de sódio. As condições principais do experimento
foram: batelada, agitação constante, concentração média de esporos presentes
na água do rio de 15.250 UFC/100 mL, pH final de 6.86 e temperatura de
230C. Após 65 min de exposição ocorreu redução aproximada de 2-log e o CT
foi de aproximadamente 114 mg.min/L (C = cloro total disponível). Após 180
min ocorreu 3 log de redução e o CT foi de 315 mg.min/L. Em estudos prévios
de inativação empregando culturas puras de esporos de B. subtilis, realizados
sob condições similares de pH e temperatura, foi reportado 3-log de redução
após 5 min de exposição e 100 mg/L de cloro disponível, resultando num CT
de 500 mg/L. As culturas puras foram mais resistentes à inativação, e, tal fato
foi atribuído à etapa de preparação dos esporos, provenientes de culturas
puras, em que são selecionados os esporos mais resistentes na etapa de
purificação. Enquanto que, sob condições naturais, os esporos selvagens](https://image.slidesharecdn.com/tesejeanette-121028154321-phpapp02/85/Tese-jeanette-45-320.jpg)

![148
para todos os tempos de contato e doses combinadas empregados, embora seja
citado no manual da USEPA (1999) que a inativação de colifagos MS2 parece
ser menos eficiente com o uso dos desinfetantes combinados do que com o uso
de desinfetantes individuais.
Sabe-se que a eficiência de inativação dos colifagos depende da cepa do
vírus usada. A cepa do colifago MS2 é citada por vários autores na literatura,
dentre eles LAZAROVA et al. (1998) como sendo muito resistente à desinfecção.
Os fagos empregados na pesquisa foram isolados de esgoto sanitário, os
mesmos eram hospedados pela cepa de E. coli CIP 55.30, entretanto, não foi
realizado estudo de identificação desses vírus.
Tem-se verificado, porém, em estudos de desinfecção realizados no
Departamento de Hidráulica e Saneamento [SOUZA (2000), COLETTI (2003),
SARTORI (2004), FERREIRA (2005)] que os colifagos isolados de esgoto
sanitário e hospedados pela E. coli CIP 55.30 apresentam características de
resistência similares à E. coli ao se empregar diferentes desinfetantes como
cloro, ozônio, radiação UV, ácido peracético e dióxido de titânio.
Aliás, quando o desinfetante empregado foi o ozônio verificou-se ligeira
superioridade de inativação dos colifagos em relação à E. coli.
Em relação à bactéria esporulada C. perfringens para alguns resultados
não ocorreu sinergismo.
Também, FINCH et al. (2000) não observou sinergismo para a bactéria
esporulada aeróbia Bacillus cereus, ao se realizar desinfecção com os processos
combinados ozônio/ cloro livre e dióxido de cloro/ cloro livre, apesar do
Bacillus cereus ter sido susceptível aos desinfetantes individualmente. Os
autores especularam que a falta de sinergismo pode ter sido devido a
diferenças bioquímicas inerentes à estrutura das membranas dessa bactéria.
Foram compilados pela USEPA (1999) resultados de desinfecção
interativa para alguns organismos, de reconhecido interesse no tratamento de
água:
a inativação de bactérias coliformes, cistos de Giardia, oocistos de
Cryptosporidium e poliovírus tipo 1 parece aumentar com os desinfetantes
combinados;](https://image.slidesharecdn.com/tesejeanette-121028154321-phpapp02/85/Tese-jeanette-162-320.jpg)



























